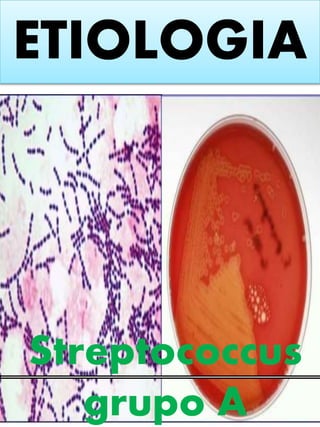
ETIOLOGIA
Streptococcus
grupo A

Incrustar presentación
Descargar para leer sin conexión














La faringitis es comúnmente causada por infecciones bacterianas como el Streptococcus del grupo A. Los síntomas incluyen dolor de garganta, fiebre y dolor al tragar. El diagnóstico se realiza mediante examen físico y pruebas como cultivos de garganta. El tratamiento consiste en antibióticos para infecciones bacterianas o medicamentos para aliviar los síntomas en caso de virus. Lavarse las manos con frecuencia puede ayudar a prevenir la propagación.